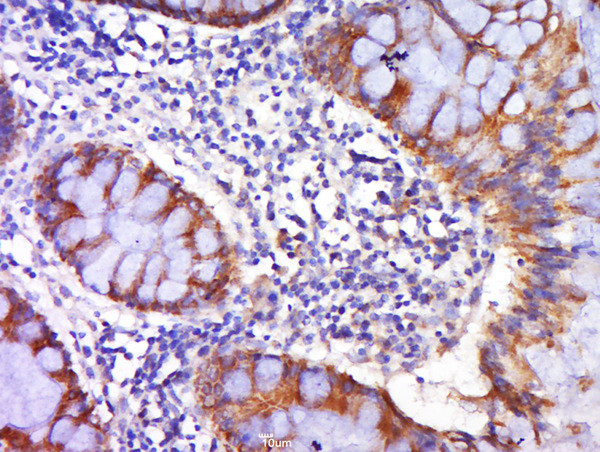
DR4 Antibody in Immunohistochemistry (Paraffin) (IHC (P))

Search
Bioss
DR4 Polyclonal Antibody
{{$productOrderCtrl.translations['antibody.pdp.commerceCard.promotion.promotions']}}
{{$productOrderCtrl.translations['antibody.pdp.commerceCard.promotion.viewpromo']}}
{{$productOrderCtrl.translations['antibody.pdp.commerceCard.promotion.promocode']}}: {{promo.promoCode}} {{promo.promoTitle}} {{promo.promoDescription}}. {{$productOrderCtrl.translations['antibody.pdp.commerceCard.promotion.learnmore']}}
图: 1 / 3
DR4 Antibody (BS-0591R) in IHC (P)



产品信息
BS-0591R
种属反应
宿主/亚型
分类
类型
抗原
偶联物
形式
浓度
规格
纯化类型
保存液
内含物
保存条件
运输条件
靶标信息
TRAIL-R1 (CD261, DR4) is a type I transmembrane protein, also called TRAIL receptor 1. The ligand for this DR4 death receptor has been identified and termed TRAIL, which is a member of the TNF family. DR4, as many other receptors (Fas, TNFR1, etc.), mediates apoptosis and NF kappaB activation in many cells and tissues. Apoptosis, a programmed cell death, is a operating process in normal cellular differentiation and development of multicellular organisms. Apoptosis is induced by coupled of certain cytokines (TNF family - TNF, Fas ligand) and their death domain containing receptors (TNFR1, Fas receptor).
仅用于科研。不用于诊断过程。未经明确授权不得转售。
篇参考文献 (0)
生物信息学
蛋白别名: CD261; cytotoxic TRAIL receptor; Death receptor 4; MGC9365; sCD261; soluble CD261; soluble TRAIL; sTRAIL; TNF-related apoptosis-inducing ligand receptor 1; TRAIL R1; TRAIL receptor 1; TRAIL-R1; Tumor necrosis factor receptor superfamily member 10A; tumor necrosis factor receptor superfamily, member 10a; unnamed protein product
基因别名: APO2; CD261; DR4; TNFRSF10A; TRAILR-1; TRAILR1
UniProt ID: (Human) O00220
Entrez Gene ID: (Human) 8797